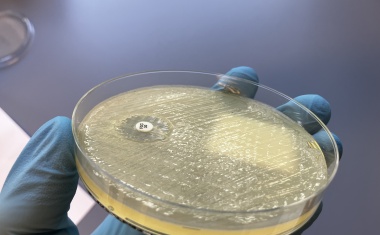
Photo

Händehygiene als Schlüssel zur Infektionsprävention im medizinischen Umfeld
Kleine Unterbrechung, große Wirkung: Warum die 30 Sekunden zwischen zwei Patienten die wichtigste halbe Minute des Tages sein kann.

Kleine Unterbrechung, große Wirkung: Warum die 30 Sekunden zwischen zwei Patienten die wichtigste halbe Minute des Tages sein kann.

In Gesundheitsdienst und Wohlfahrtspflege sind Desinfektionsmittel zur Infektionsprävention unverzichtbar.

Welchen Einfluss hat die Wassertemperatur, die Waschdauer und die Wassermenge auf das Händewaschen? Zwei Studien der Medizinischen Universität Wien zeigen überraschende Ergebnisse.

Die Anforderungen an Hygieneprodukte und Infektionsprävention in Einrichtungen des Gesundheitswesens steigen kontinuierlich.

Der nächste Meilenstein des Projekts ist erreicht.

Mehrere hundert Mitarbeitende aus dem Pflegebereich und dem ärztlichen Dienst, zudem auch zahlreiche Patienten und Besucher, besuchten am 28. August im Rahmen des jährlichen Aktionstages für "Saubere Hände" den Stand im Foyer der Zentralklinik.

Innovative Lösungen für Hygiene und Raumluftqualität sind unverzichtbar für gesundheitsfördernde Bedingungen im Krankenhaus.

Ein Händedruck kann krank machen – Die Kliniken der Stiftung Hospital zum Heiligen Geist setzen auf Sicherheit.

Mit elf Landkreisen ist das MRE-Netz Regio Rhein-Ahr nun größtes Netzwerk für Infektionsschutz und multiresistente Erreger in Nordrhein-Westfalen und Rheinland-Pfalz.

Das Universitätsklinikum Halle (Saale) wurde mit dem Goldzertifikat der bundesweiten „Aktion Saubere Hände“ ausgezeichnet.

Im Jahr 2026 verleiht die Rudolf Schülke Stiftung erneut ihren Hygiene-Preis für herausragende wissenschaftliche Arbeiten in den Bereichen Hygiene, Infektionsprävention und Öffentliche Gesundheit.

Die Bundesärztekammer hat Prof. Dr. med. Martin Exner, emeritierter Professor von der Universität Bonn, mit der Paracelsus-Medaille ausgezeichnet.

Die Medizinische Hochschule Hannover erinnert an den Welttag der Händehygiene.

Wirksame Barriere oder nur Kosmetik? Gram-negative Bakterien und ihre Resistenzen rücken zu Recht immer mehr in den Fokus der Aufmerksamkeit.

Unterstützung der WHO-Initiative zum World Hand Hygiene Day am 5. Mai

Weg vom Image der „Hygiene-Polizei“: Der weltweit erste und bisher einzige Hygiene-Kanal verändert die Kommunikation auf Social Media.

Die interaktive Schulung von Tork, bei der via VR-Brille die fünf Momente der Händehygiene trainiert werden, unterstützt bei der Vertiefung des Theoriewissens.

Seit Anfang April setzen die Paracelsus Kliniken mit einer neuen Hygienekampagne einen entscheidenden Schritt zur Verbesserung der Patientensicherheit in deutschen Gesundheitseinrichtungen.

Diako erreicht wieder höchstes Level bei bundesweiter Initiative „Aktion Saubere Hände“.

Warum die Herkunft von Einmalhandschuhen mehr über Versorgungssicherheit verrät, als man denkt. Heute liegt die Lösung näher als gedacht.

Das Hepatitis-A-Virus (HAV) ist einer der Hauptverursacher viraler Hepatitis und für schätzungsweise 159.000 Infektionen und 39.000 Todesfälle jährlich verantwortlich. Um einer Ansteckung vorzubeugen, sollten Oberflächen desinfiziert werden, besonders bei hohen Infektionszahlen.

Das GLG Werner Forßmann Klinikum Eberswalde wurde für seine guten Leistungen in der Händehygiene mit dem Bronze-Zertifikat der Aktion „Saubere Hände“ ausgezeichnet.

Hygiene und Nachhaltigkeit: Ein Thema für alle Krankenhäuser

Die Lahn-Dill-Kliniken wurden mit dem renommierten Gold-Zertifikat der bundesweiten Initiative „Aktion Saubere Hände“ ausgezeichnet.

Die Aufbereitung von Medizinprodukten (MP) und die Sterilgutversorgung spielen eine zentrale Rolle in Krankenhäusern, um Infektionen zu vermeiden.

In einer gemeinsamen Stellungnahme fordern Fachgesellschaften eine „Verankerung der praktischen Umsetzung“ von Hygiene für eine effektive Infektionsprävention.
Ein Forschungsteam des Helmholtz-Instituts für One Health (HIOH) hat die Verbreitung und Eigenschaften von antibiotikaresistenten Bakterien in der Ostsee untersucht.

„Die Stärkung des Infektionsschutzes ist eine wichtige Aufgabe. Die Prävention muss dabei an erster Stelle stehen“, sagte Dr. Ute Teichert, Leiterin der Abteilung Öffentliche Gesundheit im Bundesgesundheitsministerium, auf dem 13. Hygieneforum des Bundesverbandes Medizintechnologie am 12. Dezember 2024.

Krankenhauskeime, insbesondere multiresistente Erreger, stellen für Patienten sowie für das Gesundheitssystem eine große Belastung dar.

Personen auf Intensivstationen gelten als besonders gefährdet durch Krankenhausinfektionen. Um Schwerstkranke zu schützen, sind die hygienischen Vorkehrungen sehr hoch.

Lalita Ramakrishnan ist am Freitag, 8. November 2024 in Berlin mit dem mit 120.000 Euro dotierten Robert-Koch-Preis ausgezeichnet worden.

In der westlichen Welt halten sich die Menschen durchschnittlich zwischen 80 % und 90 % ihrer Zeit in Innenräumen auf. Die Raumluftqualität ist daher für Gesundheit und Wohlbefinden wichtig.

Das Hygieneverhalten der Menschen in Deutschland hat sich in den letzten Jahren weiter verbessert.

Zum 1. Oktober 2024 übernimmt Univ.-Prof. Dr. Frank Günther die Leitung der Abteilung für Hygiene und Infektionsprävention an der Universitätsmedizin Mainz.

Das Evangelische Amalie Sieveking Krankenhaus in Hamburg-Volksdorf ist mit der höchsten Auszeichnung der bundesweiten „Aktion Saubere Hände“ – dem Zertifikat in Gold - ausgezeichnet worden.



































